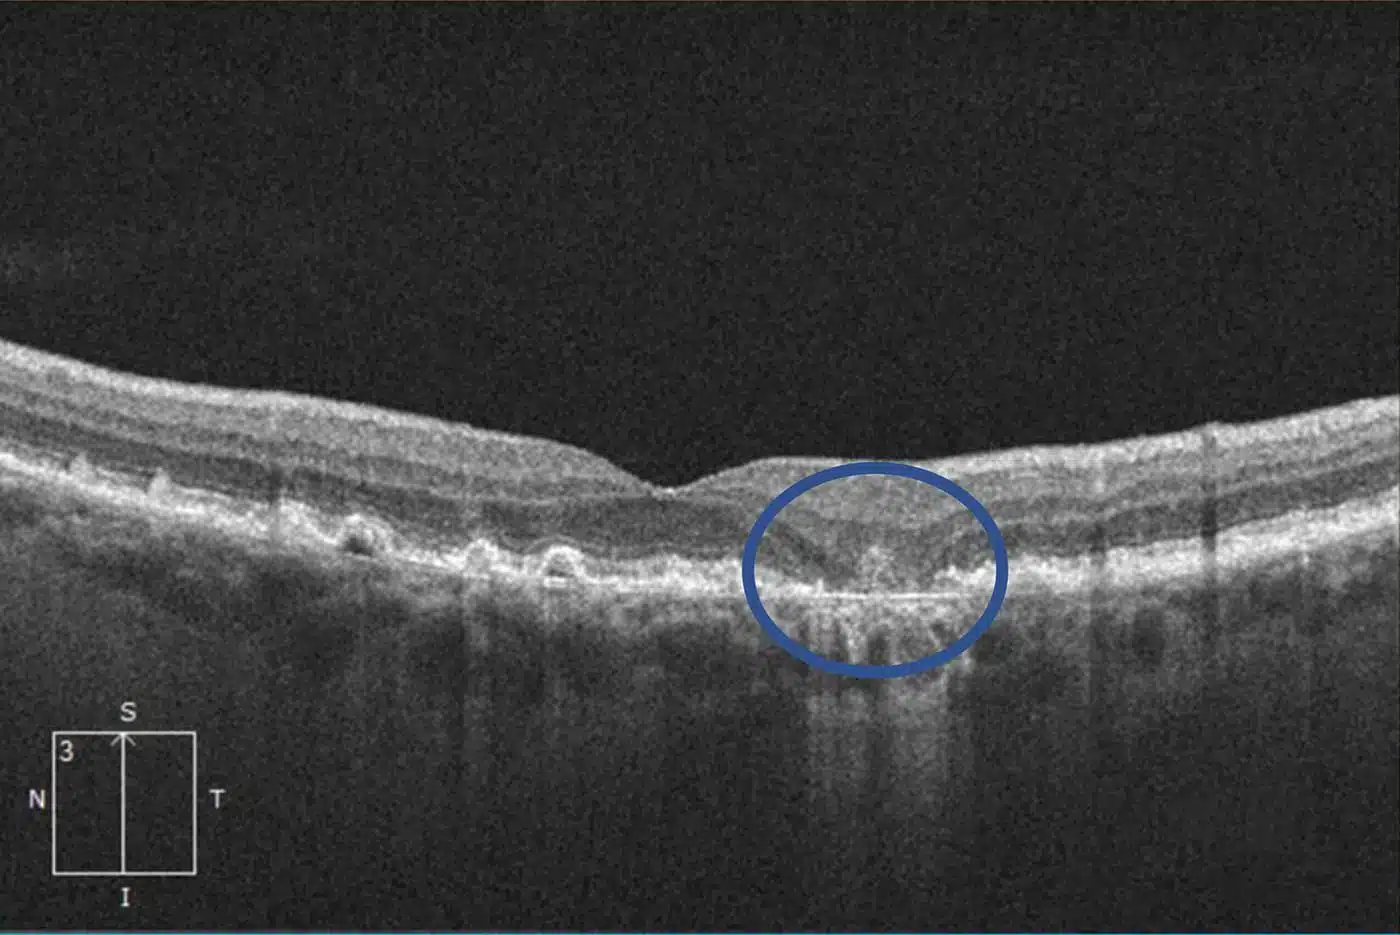
Syfovre Injections 5 Retinal atrophy causing a blind spot near the central vision in Macular Degeneration.

Syfovre and Izervay Treatment for Dry Macular Degeneration in Sarasota, FL
FDA-approved injections that can slow vision loss from advanced dry AMD.
Syfovre and Izervay are the first treatment proven to slow the progression of geographic atrophy, an advanced form of dry macular degeneration. Our retina specialists evaluate whether you are a good candidate for these medications and provide personalized treatment plans to help preserve your central vision for as long as possible.
A Breakthrough Dry Macular Degeneration Treatment Offers Renewed Hope
For the first time ever, two treatments for dry age related macular degeneration (AMD) has been approved by the FDA. The new drugs, called Syfovre and Izervay, and those that follow them, will likely lead to prevention of blindness in millions of Americans who would otherwise lose their sight to this progressive disease. If you or anyone you know is losing vision due to macular degeneration in Sarasota, Florida, please read on and call us to schedule a consultation.

Dry Macular Degeneration & Vision Loss
Dry macular degeneration is a leading cause of vision loss in people over the age of 50, and its prevalence is expected to increase as the population ages. According to the National Eye Institute, approximately 11 million people in the United States have some form of macular degeneration, and about 90% of those cases are the dry form.
With advanced dry macular degeneration, retinal atrophy leads to blind spots in the central vision that enlarge over time
The severity and speed of vision loss from dry macular degeneration can vary widely between individuals. Intermediate cases may have progressive difficulty with reading or driving. Patients who develop advanced dry macular degeneration experience one or more slowly-expanding blind spots in their central vision. In some cases, the disease leads to severe vision loss or blindness.
Dry macular degeneration can interfere with critical life activities like reading, driving, and recognizing faces.
Up until now, no treatments for dry macular degeneration existed. Medical interventions were focused solely on prevention and low vision aides. These recommendations included:
- Lifestyle changes: Quitting smoking, maintaining a healthy diet and exercise routine, and managing any underlying health conditions can help to reduce the risk of macular degeneration.
- Nutritional supplements: The second Age-Related Eye Disease Study (AREDS2) found that a combination of vitamins C and E, Lutein, Zeaxanthin, zinc, and copper can slow down the progression of the disease in patients with intermediate or advanced dry macular degeneration.
- Low vision aids: Lifestyle modifications, magnifying glasses, telescopes, and computer software, can help people with macular degeneration to perform daily activities more easily.
Syfovre and Izervay – FDA Approved Treatments for Dry Macular Degeneration
Starting in 2023, the FDA has approved the first medications to treat dry age related macular degeneration (AMD), called Syfovre and Izervay. Both drugs are inhibitors of complement, a component of the body’s immune system that plays a role in the progression of macular degeneration. Scientists first noticed the role of complement in dry AMD when conducting genetic testing on patients with the condition. People with mutations in the genes for complement were found to be at higher risk for blindness from macular degeneration.
Retinal atrophy causing a blind spot near the central vision.
Since that time, several complement inhibitors have been developed and are in various stages of testing. Syfovre was the first to gain FDA approval, followed closely by Izervay. Both having demonstrated that it can reduce the growth of blind spots from advanced dry macular degeneration by about 20% over two years. Many patients will retain their ability to read or drive as a result of this medication.
Syfovre and Izervay are delivered by injection into the eye every 1-2 months. While the most commonly-reported side effects are mild, complement inhibitors are known to increase the risk of developing leakage or bleeding in the retina, known as wet AMD. Patients receiving the injections over two years developed wet AMD in 7-12% of the studied cases, compared to 3% of those not receiving the treatment. Thankfully, there are excellent treatments available for wet age related macular degeneration.
Additional complement inhibitors are in various stages of development. Incremental improvements in strength and efficacy are expected as we get more experience with this class of medication.
Where to Get Syfovre and Izervay Treatment for Dry Macular Degeneration in Sarasota and Venice
You can receive Syfovre and Izervay injections for advanced dry macular degeneration at our Shane Retina locations throughout Sarasota and Venice, Florida. Each office provides specialized evaluation, advanced retinal imaging, and ongoing injection therapy for patients with geographic atrophy due to dry AMD.
Sarasota - University Parkway Office
Located just west of I-75 on University Parkway in University Health Park.
Our University Parkway location serves patients from Sarasota, Lakewood Ranch, Bradenton, and surrounding areas of Manatee County. This office provides evaluation and ongoing treatment for advanced dry macular degeneration, including Syfovre and Izervay injections for patients with geographic atrophy.
Sarasota - South Tamiami Trail Office
Located on South Tamiami Trail just south of Bee Ridge Road.
Our South Tamiami Trail location serves patients throughout Sarasota, Siesta Key, and nearby Sarasota County communities. Patients at this office receive personalized treatment plans for advanced dry macular degeneration, including regular Syfovre or Izervay injections and close monitoring for treatment response.
Venice Retina Office
Located in central Venice near Venetia Bay Boulevard.
Patients in Venice, North Port, Englewood, and surrounding areas of southern Sarasota County can receive Syfovre and Izervay treatment for dry macular degeneration at this location. Our team provides ongoing injection therapy and careful monitoring to help slow progression of geographic atrophy and preserve central vision.
If you suffer from dry macular degeneration we encourage you to take advantage of these exciting new advances in medical technology. Call us today at (941) 351-1200 to schedule your Syfovre and Izervay consultation!
Syfovre and Izervay FAQs
What are Syfovre and Izervay used for?
Syfovre and Izervay are FDA-approved injectable medications used to treat geographic atrophy, an advanced form of dry macular degeneration. They are designed to slow the progression of retinal cell loss that leads to enlarging blind spots in central vision.
Geographic atrophy occurs when the light-sensitive cells in the macula gradually deteriorate. Until recently, there were no approved treatments to slow this process. Syfovre and Izervay are the first medications proven to reduce the rate at which these blind spots expand.
These treatments do not restore vision that has already been lost, but they can help preserve remaining central vision for a longer period of time in patients with advanced dry AMD.
These treatments are not indicated for early or intermediate dry macular degeneration and are specifically used for patients with geographic atrophy in more advanced stages of the disease.
What is geographic atrophy?
Geographic atrophy is an advanced stage of dry macular degeneration in which areas of the retina gradually lose their light-sensitive cells. As these cells deteriorate, permanent blind spots develop in the center of vision.
In geographic atrophy, the retinal cells responsible for detailed sight slowly die, a process known as atrophy. Over time, these areas of damage expand, causing increasing difficulty with reading, driving, recognizing faces, and performing other activities that rely on central vision.
Unlike wet macular degeneration, geographic atrophy does not involve abnormal blood vessel growth or bleeding. Instead, it represents progressive cell loss within the macula itself.
Geographic atrophy is irreversible, meaning the damaged retinal tissue cannot recover. However, newer treatments such as complement inhibitor injections are designed to slow the enlargement of these atrophic areas and help preserve remaining vision for as long as possible.
How do Syfovre and Izervay work?
Syfovre and Izervay work by blocking part of the complement system, a component of the body’s immune response that plays a role in the progression of geographic atrophy.
In dry macular degeneration, overactivation of the complement pathway contributes to inflammation and gradual destruction of retinal cells. This ongoing immune activity accelerates the enlargement of atrophic areas in the macula.
Syfovre and Izervay are complement inhibitors. By reducing complement activity inside the eye, these medications slow the rate at which retinal cells are damaged. Clinical trials have shown that both drugs reduce the growth of geographic atrophy lesions by approximately 20 percent over two years compared to no treatment.
These medications do not reverse existing damage or restore lost vision. Their purpose is to preserve remaining central vision by slowing further progression of retinal cell loss.
How effective are Syfovre and Izervay?
Syfovre and Izervay have been shown in clinical trials to slow the progression of geographic atrophy by approximately 20 percent over two years compared to no treatment. Their primary benefit is reducing how quickly blind spots enlarge in patients with advanced dry macular degeneration.
Both medications were studied in large, controlled trials where patients received regular injections over a two-year period. The results demonstrated a measurable reduction in the growth rate of atrophic areas in the macula. Slowing this progression may help preserve reading and driving vision for a longer period of time.
It is important to understand that these medications do not restore vision that has already been lost. Their benefit lies in protecting remaining retinal cells and delaying further decline.
Individual results vary depending on disease stage, location of geographic atrophy, and overall retinal health. A retina specialist can determine whether a patient is likely to benefit from treatment based on imaging and clinical findings.
How are Syfovre and Izervay administered?
Syfovre and Izervay are administered as intravitreal injections, meaning the medication is injected directly into the vitreous cavity of the eye. The procedure is performed in the office by a specialist under sterile conditions.
Before the injection, the eye is numbed with anesthetic drops and cleaned with antiseptic to reduce the risk of infection. The injection itself takes only a few seconds. Most patients feel pressure rather than pain during the procedure.
These medications are not taken orally and cannot be delivered as eye drops. Direct injection into the eye allows the drug to reach the retina at therapeutic levels.
After the injection, patients are monitored briefly and can usually return home the same day. Mild redness, irritation, or temporary floaters may occur, but serious complications are uncommon.
How often do I need Syfovre or Izervay injections?
The frequency of Syfovre or Izervay injections depends on the specific medication and your retina specialist’s recommendation.
Syfovre is FDA-approved for either monthly injections or injections every other month. Izervay is FDA-approved for monthly injections, although some retina specialists may extend the interval in carefully selected patients based on response and risk profile.
The injection schedule is determined by several factors, including the size and location of geographic atrophy, how quickly it is progressing, and how your retina responds to treatment over time. Regular retinal imaging is used to monitor changes and adjust the interval when appropriate.
Because geographic atrophy is a chronic condition, ongoing treatment is typically required to maintain the slowing effect of the medication.
Do Syfovre and Izervay improve vision?
Syfovre and Izervay are not designed to improve vision. Their primary purpose is to slow the progression of geographic atrophy in advanced dry macular degeneration.
These medications work by reducing the rate at which retinal cells are lost. By slowing the enlargement of blind spots in central vision, they help preserve the vision that remains. In clinical trials, the benefit was measured by reduced growth of atrophic areas rather than improvement in visual acuity.
Some patients may feel that their vision remains more stable over time compared to the expected natural progression of the disease. However, these treatments do not reverse existing retinal damage or restore vision that has already been lost.
The goal of therapy is preservation, not restoration. Slowing disease progression can help maintain independence and daily function for a longer period of time.
Are Syfovre and Izervay injections safe?
Syfovre and Izervay have been studied in large clinical trials and are considered generally safe when administered by a trained retina specialist. As with any intraocular injection, however, there are risks that patients should understand.
The most common side effects are mild and may include temporary redness, irritation, floaters, or small areas of surface bleeding on the eye. These symptoms typically resolve on their own.
Because these medications affect the complement system, they carry a known risk of developing wet macular degeneration during treatment. In clinical trials, wet AMD developed in approximately 7 to 12 percent of treated patients over two years, compared to about 3 percent in untreated groups. If wet AMD develops, it can be treated with anti-VEGF injections.
Rare but serious complications of any eye injection include infection inside the eye, known as endophthalmitis, inflammation, or retinal detachment. These events are uncommon but require immediate medical attention if symptoms such as severe pain or sudden vision loss occur.
Your retina specialist will carefully evaluate whether the benefits of slowing geographic atrophy outweigh the potential risks in your specific case.
When were Syfovre and Izervay approved?
Syfovre was approved by the U.S. Food and Drug Administration in February 2023 for the treatment of geographic atrophy secondary to dry age-related macular degeneration. It was the first FDA-approved medication specifically indicated for this condition.
Izervay was approved shortly afterward, in August 2023, also for the treatment of geographic atrophy due to dry macular degeneration. Its approval marked the second complement inhibitor available for this advanced stage of the disease.
The approval of these medications represented a major milestone in retina care, as they were the first treatments shown to slow the progression of geographic atrophy.
Does Medicare cover Syfovre and Izervay?
Yes, Medicare typically covers Syfovre and Izervay under Medicare Part B because they are physician-administered injectable medications given in a medical office setting.
Medicare generally covers 80 percent of the approved cost after the Part B deductible is met. If you have supplemental insurance, it may cover some or all of the remaining 20 percent. Coverage can vary depending on your specific plan and whether prior authorization is required.
Because these medications are relatively new and high-cost, retina offices usually perform a benefits investigation before starting treatment. This helps determine your out-of-pocket responsibility and whether additional co-pay assistance programs are available.
How much do Syfovre and Izervay cost?
The cost of Syfovre and Izervay can vary depending on insurance coverage, geographic region, and individual treatment schedules. These are specialty medications, and the retail price per injection is typically several thousand dollars before insurance coverage.
For patients with Medicare Part B, Medicare generally covers 80 percent of the approved cost after the deductible is met. If you have supplemental insurance, it may cover some or all of the remaining balance. Commercial insurance plans may also provide coverage, but prior authorization is often required.
Because out-of-pocket costs can differ significantly between patients, retina practices typically perform a benefits investigation before starting treatment. In addition, manufacturer-sponsored patient assistance and co-pay support programs may be available to help reduce financial burden for eligible patients.
Before beginning therapy, your retina specialist’s office will review your coverage and discuss expected costs so you can make an informed decision about treatment.
How much do Syfovre and Izervay cost?
The cost of Syfovre and Izervay can vary depending on insurance coverage, geographic region, and individual treatment schedules. These are specialty medications, and the retail price per injection is typically several thousand dollars before insurance coverage.
For patients with Medicare Part B, Medicare generally covers 80 percent of the approved cost after the deductible is met. If you have supplemental insurance, it may cover some or all of the remaining balance. Commercial insurance plans may also provide coverage, but prior authorization is often required.
Because out-of-pocket costs can differ significantly between patients, retina practices typically perform a benefits investigation before starting treatment. In addition, manufacturer-sponsored patient assistance and co-pay support programs may be available to help reduce financial burden for eligible patients.
Before beginning therapy, your retina specialist’s office will review your coverage and discuss expected costs so you can make an informed decision about treatment.
How do you pronounce Syfovre and Izervay?
Syfovre is pronounced ‘Sigh-fove-ree’.
Izervay is procounced ‘eye-zer-vay
Despite the cold inevitability of old age conditions like dry macular degeneration, there have been great breakthroughs in medicine, and these inspire hope.
– Dr. Thomas Shane,
Dry Macular Degeneration Specialist and founder of Shane Retina
Get Treatment for Dry Macular Degeneration Today!
Syfovre and Izervay mark the arrival of a brand new class of medications FDA-approved for the treatment of dry age related macular degeneration heralds a new era in the prevention of blindness in America. If you or someone you know has macular degeneration, you should seek consultation with a retina specialist to discuss these exciting new treatment options.
At Shane Retina, we are available daily with the newest and best treatment options for macular degeneration in Sarasota and Manatee counties. Book your macular evaluation and counseling today!